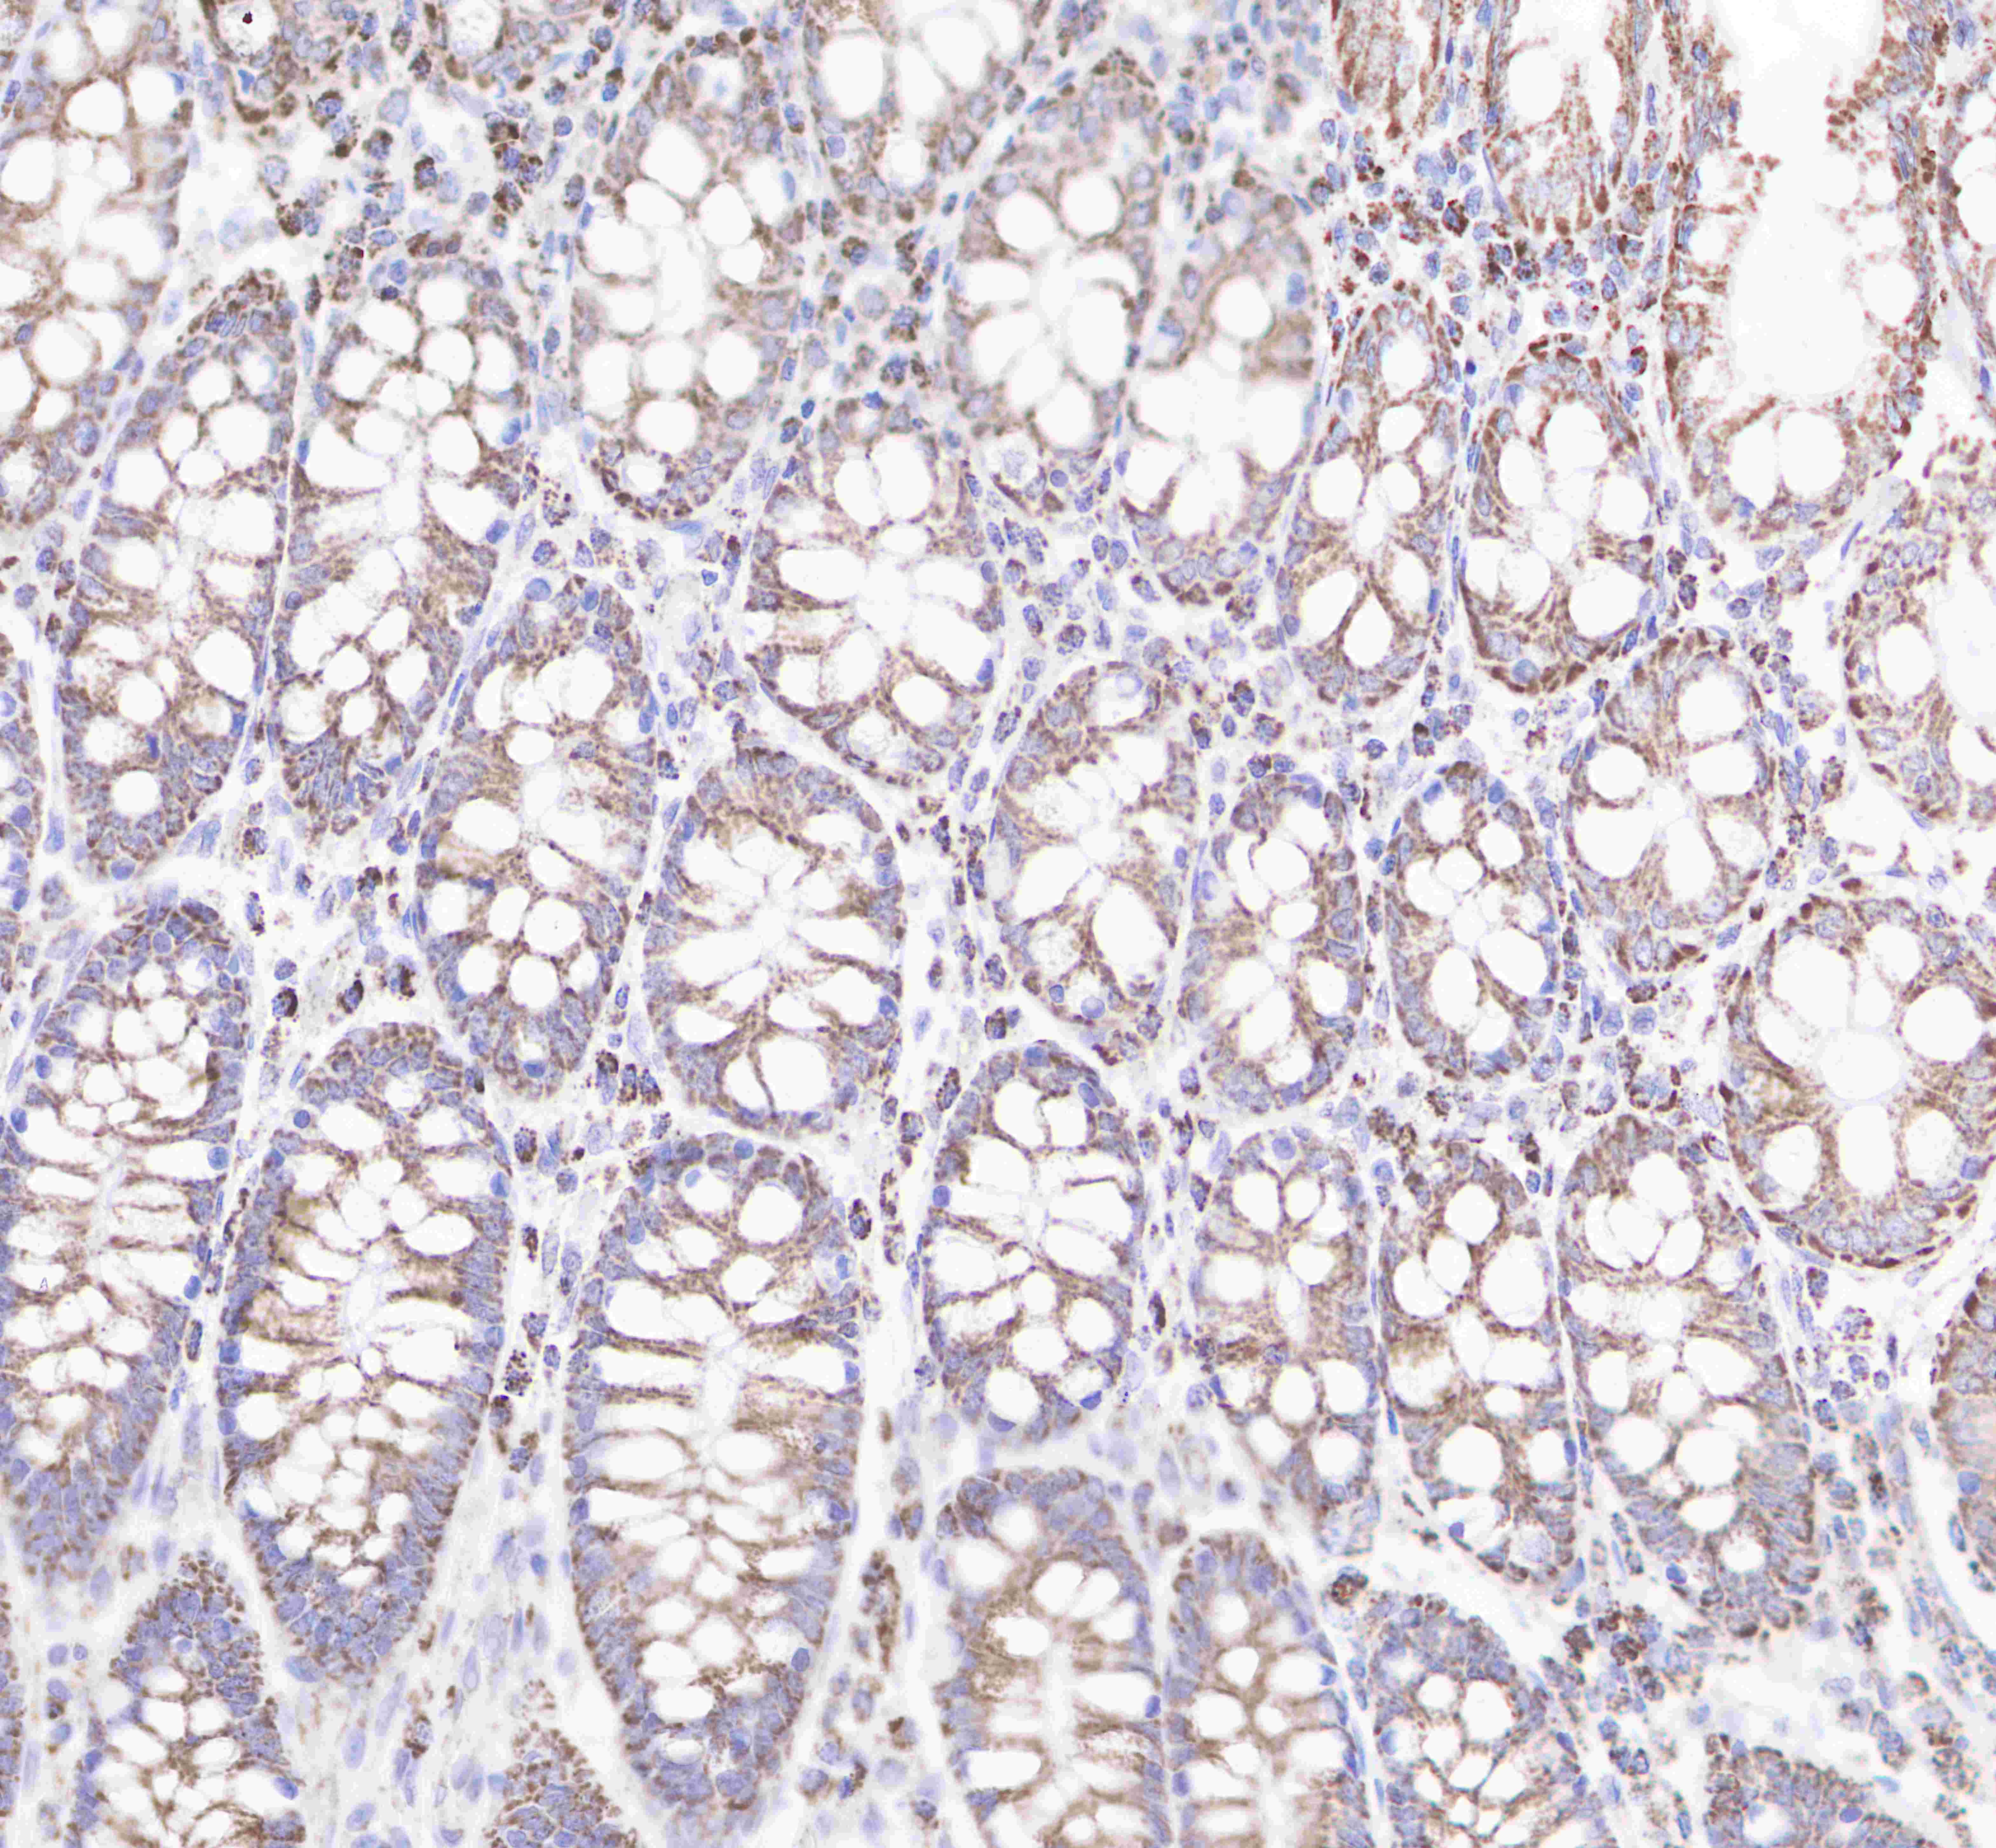

Product Specification
| Host |
Rabbit |
| Antigen |
VDAC1 |
| Synonyms |
Outer mitochondrial membrane protein porin 1; Plasmalemmal porin; Porin 31HL; Porin 31HM |
| Immunogen |
Recombinant Protein |
| Accession |
P21796 |
| Clone Number |
SDT-R013 |
| Antibody Type |
Rabbit mAb |
| Application |
WB, IHC-P |
| Reactivity |
Hu, Ms, Rt |
| Purification |
Protein A |
| Concentration |
0.5mg/ml |
| Molecular Weight |
32kDa |
| Conjugation |
Unconjugated |
| Physical Appearance |
Liquid |
| Storage Buffer |
PBS, 40% Glycerol, 0.05%BSA, 0.03% Proclin 300 |
| Stability & Storage |
12 months from date of receipt / reconstitution, -20 °C as supplied. |
Dilution
| application |
dilution |
species |
| IHC-P |
1:2000 |
|
| WB |
1:1000-1:10000 |
|
Background
Voltage-dependent anion-selective channel 1 (VDAC-1) is a beta barrel protein that in humans is encoded by the VDAC1 gene located on chromosome 5. It forms an ion channel in the outer mitochondrial membrane (OMM) and also the outer cell membrane. In the OMM, it allows ATP to diffuse out of the mitochondria into the cytoplasm. In the cell membrane, it is involved in volume regulation. Within all eukaryotic cells, mitochondria are responsible for synthesis of ATP among other metabolite needed for cell survival. VDAC1 therefore allows for communication between the mitochondrion and the cell mediating the balance between cell metabolism and cell death. Besides metabolic permeation, VDAC1 also acts as a scaffold for proteins such as hexokinase that can in turn regulate metabolism.